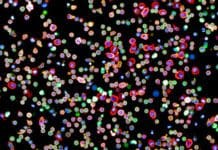

Мишо Лекиќ
Samsung ги претстави нивните најнови уреди на Galaxy Unpacked August 2022
Samsung вчера го одржа нивниот Galaxy Unpacked August 2022 настан и дефинитивно може да се каже дека имаше што да се види. Од компанијата...
Meta ги заобиколува мерките за приватност на iOS преку вградениот прелистувач во нивните апликации
Според анализата направена од страна на Феликс Краус, Meta на еден начин ги заобиколува правилата за приватност на iOS преку користење на сопствен прелистувач...
Motorola го претстави Razr 2022 кој доаѓа со Snapdragon 8+ Gen 1
Motorola, еден ден по претставувањето на новиот Galaxy Z Flip4 од Samsung, ја претстави наредната генерација од нивниот Moto на преклопување, Moto Razr 2022.
Moto...
Samsung денеска гo претставува Galaxy Z Fold4, гледајте го настанот во живо
Со почеток во 15:00 часот по македонско време, Samsung ќе го одржи нивниот Galaxy Unpacked August 2022 настан кој повторно ќе се пренесува во...
Елон Маск продаде акции од Tesla во вредност од 6,9 милијарди долари поради можниот...
Елон Маск оваа недела продаде дополнителна количина акции од Tesla, компанијата која ја основа, во вредност од скоро 7 милијарди долари, односно 6,9 милијарди....
Научници успеаја да ја направат првата целосна мапа на поврзаноста на имунолошкиот систем на...
Научници од Wellcome Sanger Institute од Британија и ETH Zurich успешно ја имаат направено првата мапа на поврзаноста на имунолошкиот систем на човекот. Потребни...
Apple го враќа процентот на батеријата кај поновите iPhone телефони
Apple во текот на вчерашниот ден ја пушти петтата бета верзија за програмерите од iOS 16 која со себе донесува една мала, но доста...
Tesla ја достигна бројката од 3 милиони произведени електрични автомобили
За време на годишното собрание на акционери, Tesla најави дека го има произведено својот 3 милионити електричен автомобил. Достигнувањето на бројката се има случено...
Netflix Games ги играат помалку од 1% од претплатниците на сервисот
Netflix при крајот на минатата година како избор на содржина воведе и игри кои корисниците можат да ги играат без дополнително плаќање, како и...
Samsung ја пушти првата бета верзија од One UI 5.0 направена на Android 13
На крајот од јуни можевме да прочитаме дека Samsung оваа година планира да ја пушти надградбата на One UI направена на наредната верзија од...
Google го започна спојувањето на Google Duo и Google Meet апликациите во една
Google во јуни најавија дека планираат да ги спојат нивните две апликации за видео разговори Google Duo, која е наменета за приватните корисници и...
Научници користат мртви пајаци како роботски раце за пренесување на мали работи
Научници од Rice Универзитетот од САД дојдоа до нестандардна идеја за искористување на умрени пајаци како роботски раце со кои би можеле да се...